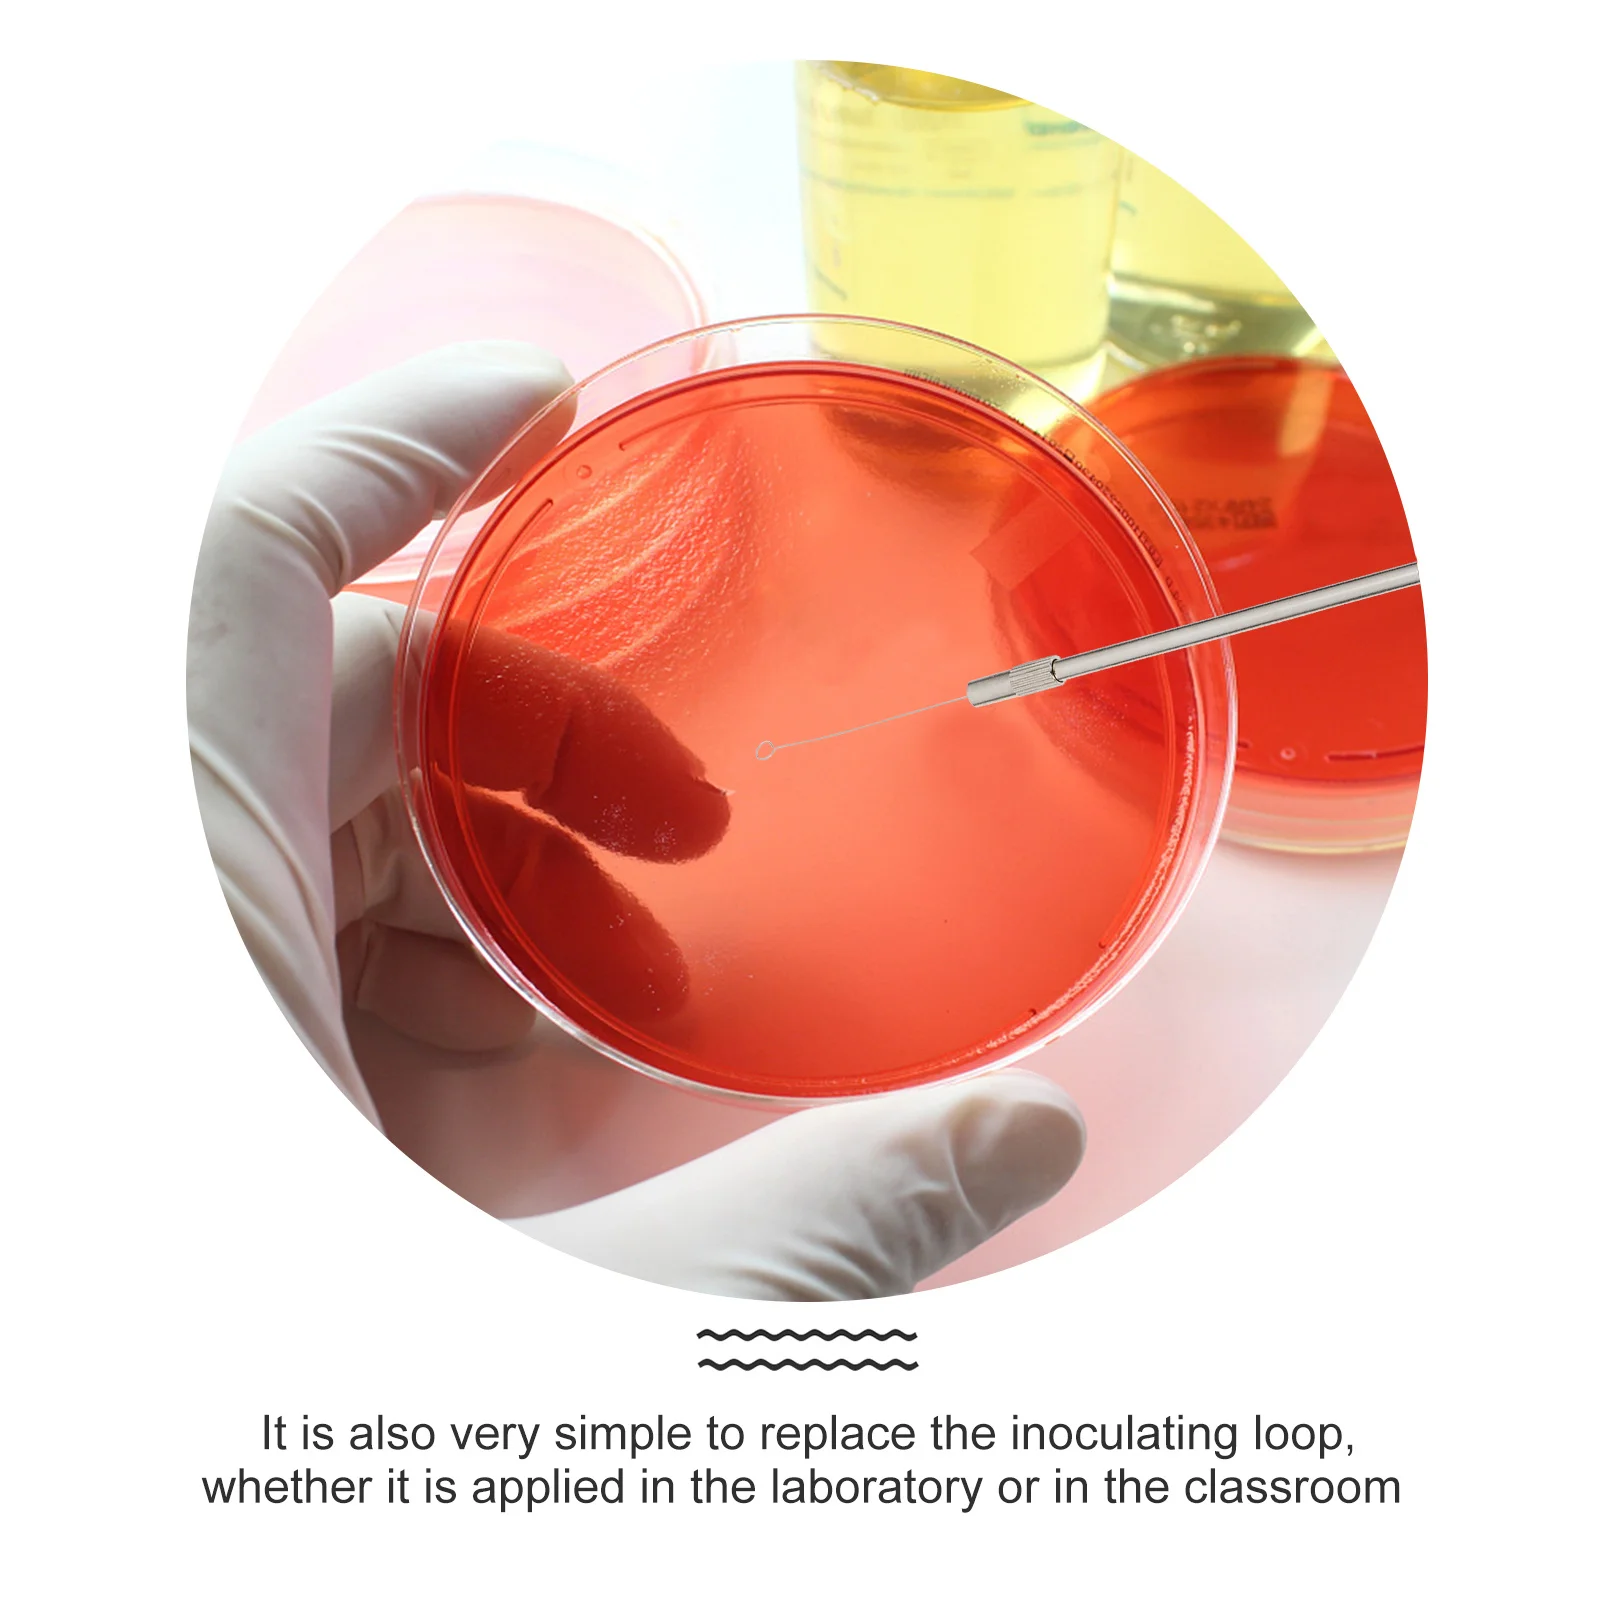

Сельское хозяйство, водная почва, умная сенсорная система
График изменения цены & курс обмена валют
Пользователи также просматривали

$60.99
Birdtree 100%Wool Cardigan Sweater Women V Neck Irregular Placket Solid Simple Slim Versatile Gentle Commute Knit Fall T3D276QD
aliexpress.com
$173.99
8-Core 9.7" For Tesla Style Android All-in-one Car Radio For Peugeot 405 2015-2020 DSP PIP Wireless CarPlay GPS Navigation 2Din
aliexpress.com
$1,009.25
110V/220V Single Head Electric Rolling Mill Jewelry Machine for Gold Silver Nuggets Pressing Equipment Jewelry Making Tool
aliexpress.com
$34.50
Dress Women Knitted Sweater Clothing For Spring Autumn 2024 New Fashion Turtleneck Solid Buttons Pullover Knee-Length Oversize
aliexpress.com
$8.09
For Trax Trx4 Bronco 1/10 Crawler Climbing Vehicle Stainless Steel Hood Decoration Sheet B Type Hood Decoration Protection
aliexpress.com
$1.78
Stopper Bumper Stopper Bumper Stopper Car Accessories Door Rubber Bumper Stopper New Arrivals For Nissan Armada (Y62)
aliexpress.com
$4.29
Women's Hat Winter Luxury Men's Hat Women's Fashion Wedding Decoration Sun Shading Leisure British Top Hat Flat Hat
aliexpress.com
$33.69
2002 New Plus Size 4XL One-piece Swimsuit Backless Deep V neck Summer Sexy Bikini Set Ladies Beach Bathing Suit Swimwear
dhgate.com
$124.25
O'MIN BASIC 3/4 Piece Snooker Cue Kit with Case with Extension 11.5mm Tip Snooker Stick Billiard Snooker Kit Stick
aliexpress.com
$19.49
Long Sleeve Tops and Pants Two Piece Set Women Zebra Print Buttoned Shirt Zipper Short Sets Summer Casual Loose Tracksuit sets
aliexpress.com
$15.06
VODOOL Gaming Headphone USB Wired Headband Earphone PC Stereo Surround Sound Headset with Mic for PS3 PS4 PC
aliexpress.com
$6.02
CASTNOO 110-220V LED UFO Flat Light Energy Saving Lamp 12W LED Bulb E27 LED Light+Bulb Lamp Holder For Indoor lighting
aliexpress.com
$0.27
45pcs Blue Style Memo Pad Kawaii Stationery Creative Cute Animal Sticky Notes School Supplies Paper Stickers
aliexpress.com
$4.43
Natural Amethysts Quartz Turquoises Lava Black Tourmaline Stone Pendant Nuggets Irregular Handmade Wired Dangle Stone Pendants
aliexpress.com
$0.49
New Arrival 100 Pcs / Bag Bonsai Four Leaf Clover Trifolium Repens Mixed Dutch Clover Bonsai Diy Home & Garden Potted Planting
aliexpress.com
$2.21
2019 new crystal from swarovski design 6565 Metallic Cap Pear-shaped Pendant for DIY jewelry
aliexpress.com
$10.14
Floral Baby Girl Qipao Silky Dress Children Chi-Pao Cheongsam Chinese New Year Costume Clothes Kids Dresses Wedding Uniform 2-16
aliexpress.com
$13.99
Glamaker Sexy off shoulder white bodycon dress Women summer elegant short dress Female slash neck party club mini dress vestidos
aliexpress.com
$6.99
Geebro Colorful Crystal Rhinestones Accessories Women Ribbed Elastic Headbands Female Bohemia Hairbands Fashion Headwear AD002
aliexpress.com
$4.99
100% NEW High Quality BLB-2 BLB 2 battery for Nokia 6590 5210 6500 6510 3610 8270 8910 8910i 8210 7650 6590i
aliexpress.com
$13.20
Womens Winter Jeans High Waist Skinny Pants Fleece Lined Elastic Waist Jeggings Casual Plus Size Jeans For Women Warm Jeans#C
aliexpress.com
$0.85
Maya Memorial Coin Pyramids Coins American Coins Mexico Aztec Gold and Silver Foreign Non-currency Coins
aliexpress.com
$419.30
Sea-Gull Heritage Chronograph Telemetre Exhibition Back Hand Wind Mechanical Men's Watch Seagull M191S White Dial
aliexpress.com
$29.37
Doorbell battery Smart Alarm System Device Wireless Infrared Anti-theft Alarm Enter Door Welcome Chime Home Shop Doorbell
aliexpress.com
$22.72
Women Casual Platform Shoes Dropshipping Pu High Heels Wedges Woman Trainers Walking Shoes Height Increasing
aliexpress.com
$20.37
Свободные прямые мужские джинсы до середины икры, летние уличные лоскутные широкие брюки с потертыми усами, хип-хоп, хлопок
aliexpress.ru